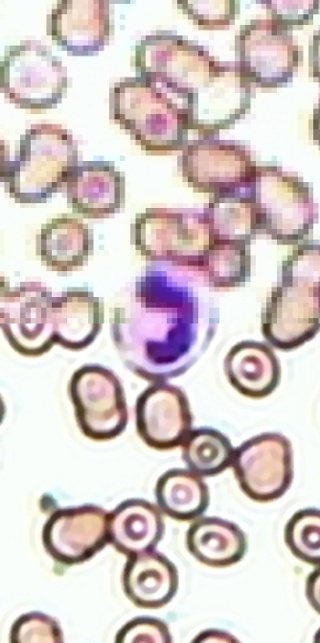

Super Resolution
Im Jahr 1977 veröffentlichte das Ehepaar Charles und Ray Eames einen neunminütigen Kurzfilm mit dem Titel "Zehn hoch" ("Powers of 10"). Der Film zeigt mit Hilfe von realen Aufnahmen und Tricktechnik eine Reise in den Mikro- und Makrokosmos. Ausgehend von einer Picknickszene entfernt sich der Betrachter mit steigender Geschwindigkeit immer weiter von der Erde, bis nur noch Galaxien zu sehen sind; auf der Rückreise zoomt die Kamera so weit in die Szene hinein, dass schließlich einzelne Atome erkennbar werden. Auch 30 Jahre nach seiner Erstausstrahlung hat das Werk nichts von seinem Reiz verloren.
Neue Technologien ermöglichen heute den immer tieferen Blick ins Weltall und in die Welt der Atome und Quarks. Doch nicht nur in der Physik, der Raumfahrt, der Medizin, sondern auch im alltäglichen Leben steigt der Bedarf an immer besseren Kameras, die zu möglichst günstigen Preisen möglichst hoch aufgelöste Bilder liefern sollen. Ein aktuelles Thema ist die automatische Videoüberwachung, bei der höhere Auflösungen die Identifikation von Personen erheblich erleichtern würden, ein anderes Anwendungsgebiet ist die hochaufgelöste Mikroskopie.
Da beim Bau von Kameras physikalische Grenzen bestehen, die verhindern, dass die Pixelgröße immer weiter reduziert werden kann (dies führt beispielsweise zu Rauschen), sind alternative Ansätze nötig, um eine Auflösungssteigerung zu erreichen. Eine bekannte softwarebasierte Lösung sind die sogenannten "Super Resolution"-Techniken. Diese sind verwandt mit verschiedenen Aufgabenstellungen aus der Bildverarbeitung. Bei der Bildrestaurierung wird auf einem einzelnen Bild gearbeitet, das durch Entfernen von Rauschen oder Unschärfe verbessert werden soll, ohne dass die Bildgröße dabei verändert wird. Bei der Bildinterpolation wird hingegen versucht, die Abmessungen eines einzelnen Eingabebildes zu vergrößern, wobei strenggenommen nicht die Auflösung, sondern nur die Bildgröße erhöht wird. Diese Aspekte werden beim Super-Resolutions-Ansatz kombiniert. Ziel ist es, ein höher aufgelöstes Bild zu berechnen, das zudem möglichst frei von Rauschen ist und im Gegensatz zu den Ergebnissen herkömmlicher Interpolationsalgorithmen auch höhere Frequenzanteile beinhaltet. Ausgangsbasis für diese Methode ist eine Sequenz von niedrig aufgelösten, im Subpixelbereich(!) räumlich zueinander verschobenen Bildern.
Für das Verständnis des Super-Resolutions-Problems ist der Entstehungsprozess dieser Aufnahmen wichtig. Häufig wird eine Digitalkamera eingesetzt.
Bei der Aufnahme kann es zu unterschiedlichen Störungen und physikalischen Einflüssen kommen, die die Bildqualität negativ beeinflussen. Mit
Hilfe eines einfachen, dynamischen Beobachtungsmodells für globale Bewegungen kann dieser Prozess nachgebildet werden (siehe rechts).
Mit den Methoden der Super Resolution versucht man nun den umgekehrten Weg zu gehen: ausgehend von einer Menge von niedrig aufgelösten Daten Y_k soll das hochaufgelöste Bild X rekonstruiert werden; es handelt sich also um ein schlecht konditioniertes Problem im Sinne von Hadamard. Klassischerweise bestehen die Super-Resolutions-Algorithmen aus drei Phasen: zunächst werden die vorliegenden, niedrig aufgelösten Bilder in Bezug auf ein Referenzbild registriert, anschließend wird in einem zweiten Schritt ein hoch aufgelöstes Bild konstruiert. In einer letzten Phase wird der Unschärfeeffekt rückgängig gemacht (Deblurring) und eventuell auftretende Fehler durch Rauschen vermindert. Teil zwei und drei dieses Prozesses sind häufig eng miteinander verwoben. Für die Lösung dieses Problems gibt es eine Vielzahl an Methoden im Orts- und Frequenzraum, von denen ich im Rahmen meiner Diplomarbeit eine Menge ausprobiert und getestet habe.
Um zum Abschluss dieses kurzen Artikels noch zu zeigen, dass sich Super Resolution tatsächlich lohnt, noch ein kleines Beispiel:

Um niedrig aufgelöste Eingabedaten zu simulieren, wird das Originalbild (links) mit einem Gaußfilter weich-gezeichnet und unterabgetastet

Einige von insgesamt 16 im Subpixelbereich verschobenen Eingabebildern nach Gaußfilterung (gemäß Abtasttheorem von Shannon) und vierfacher Unterabtastung - die schlecht aufgelösten Eingabedaten

Das Ergebnis der bilinearen Interpolation eines Eingabebildes, zu vergleichen mit dem Originalbild oben

Die Super-Resolution-Rekonstruktion auf Basis von 16 im Raster (1/4 * i, 1/4 * j), i,j=0,...,3 verschobenen Eingabebildern, dem Ergebnis der bilinearen Interpolation ist dieses Resultat in Punkto Schärfe und Detailreichtum deutlich überlegen
S. Borman and R. Stevenson. Super-resolution from image sequences - a review. Technical report, University of Notre Dame, 1998.
S. C. Park, M. K. Park and M. G. Kang. Super-resolution image reconstruction: a technical overview, IEEE Signal Processing Magazine, 20(3):21-36, May 2003.
S. Farsiu, D. Robinson, M. Elad and P. Milanfar. Advances and Challenges in Super-Resolution, International Journal of Imaging Systems and Technology, Volume 14, no 2, pp. 47-57, August 2004

Oben: Modell für den Bildgebungsprozess einer Digitalkamera mit den Operatoren M_k, B_k, D: die Kamera wird über einer Szene X bewegt (M_k). Beim Aufnahmeprozess kann es zu physikalischen Störungen kommen, die die Bildqualität negativ beeinflussen, darunter Unschärfe durch Bewegung oder falsches Fokussieren (B_k), Diskretisieren (D_k) und additives Rauschen. Anstelle von X erhält man (mehrere) degenerierte Fassungen Y_k. [nach Farsiu 2004]
Unten: Anwendung von SR-Verfahren auf Mikroskopiedaten von Erythrozyten (rote Blutkörperchen, im Bild braun) und Leukozyten (weiße Blutkörperchen, im Bild violett). Zum Vergleich ist in der oberen Bildhälfte das Resultat durch bilineare Interpolation eines Eingabebildes gezeigt.